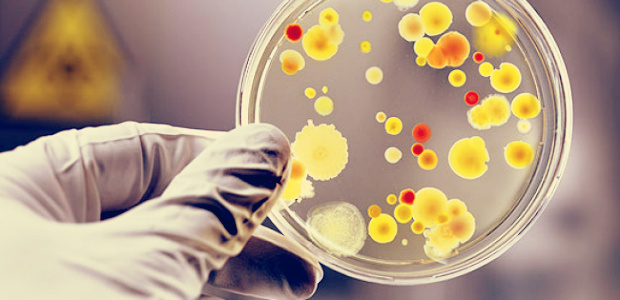
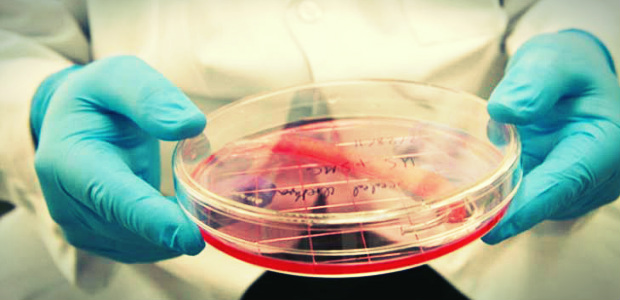

Departments
-

Agricultural Sciences
-

Architecture
-
Biology
-

Economics, Management and Institutions
-

Pharmacy
-

Physics "Ettore Pancini"
-

Law
-

Chemical, Materials and Production Engineering
-

Civil, Building and Enviromental Engineering
-

Electrical Engineering and Information Technology
-

Industrial Engineering
-

Mathematics and Application "Renato Caccioppoli"
-

Clinical Medicine and Surgery
-
Molecular Medicine and Medical Biotechnologies
-

Veterinary Medicine and Animal Production
-

Neuroscience, Reproductive Sciences and Dentistry
-

Public Health
-

Advanced Biomedical Sciences
-

Chemical Sciences
-

Earth, Environment and Resources Sciences
-

Economics and Statistics
-

Translational Medicine
-

Political Sciences
-

Social Sciences
-

Structures for Engineering and Architecture
-

Humanities